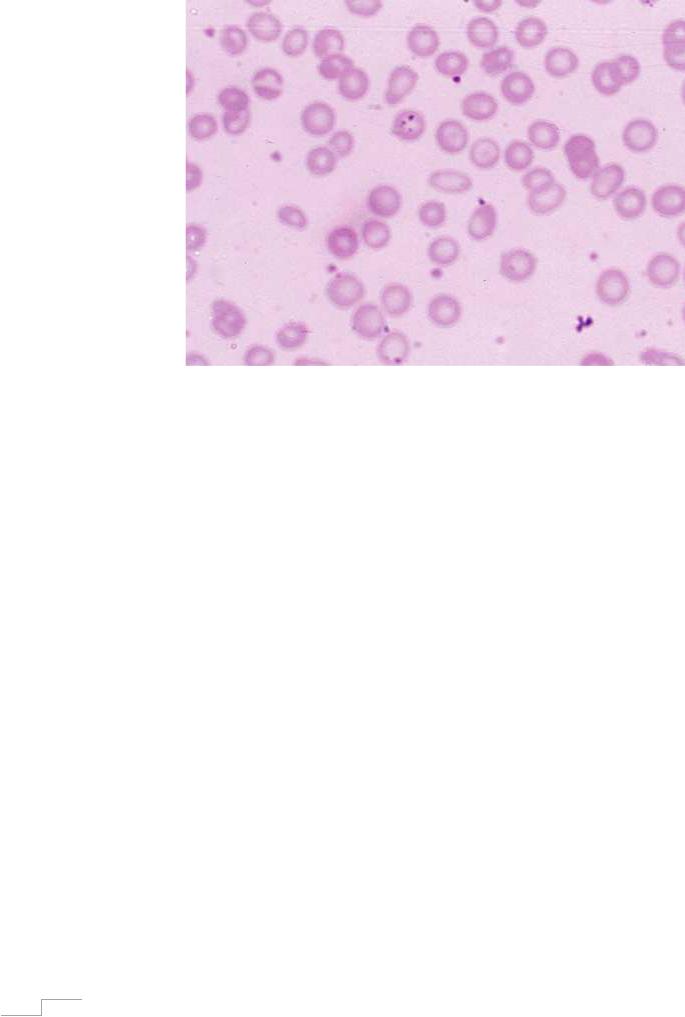

Материал: blood4

Рисунок 2. Ногтевая пластина больного железодефицитной анемией.
Следует также отметить, что при длительном дефиците железа отмечается:
∙невосстанавливаемое разрушение зубной эмали,
∙происходит задержка умственного и физического развития детей,
∙повышенная восприимчивость организма к различным инфекциям,
∙сопутствующая эндокринологическая патология,
∙нарушение менструального цикла у женщин.
При наличии описываемой клинической картины болезни обязательным
для подтверждения диагноза железодефицитной анемии является наличие
следующих лабораторных критериев:
∙в общеклиническом анализе крови – гипохромная анемия
(соотношение просветленного центра эритроцита к окрашенной
периферии – 2-3:1, при норме 1:2), микроцитоз (рис. 3);
∙в биохимическом исследовании - снижение уровня сывороточного железа, трансферрина и ферритина, повышение общей железосвязывающей способности сыворотки.
15
Рисунок 3. Гипохромия (интенсивность окрашивания эритроцитов снижена, соотношение просветленного центра эритроцита к окрашенной периферии – 2-3:1) и микроцитоз (эритроциты меньшего размера) при железодефицитной анемии.
Как правило, результаты приведенных исследований достаточно ясно отражают наличие у больного железодефицитного состояния. Тем не менее,
дополнительными методами доказательств наличия у пациентов дефицита железа может служить десфераловая проба, когда исследуют содержание железа в моче после введения десферала. В норме, железо в моче повышается, поскольку десферал его связывает и выводит из организма. При дефиците железа после этой пробы количество железа в моче не увеличивается.
При оценке картины костного мозга больных железодефицитной анемией регистрируется эритроидная гиперплазия и снижение количества сидеробластов (эритроидных клеток, содержащих железо) вплоть до полного их отсутствия (рис. 4).
16

Рисунок 4. Мазок красного костного мозга при железодефицитной анемии. Нормобластическая эритроидная гиперплазия. Гемосидерин отсутствует. Количество сидеробластов снижено (менее 10%). Нормоциты уменьшены в размере, с зазубренными ободками цитоплазмы, содержащей незначительное количество гемоглобина.
Лечение. Лечение железодефицитной анемии имеет несколько точек
приложения. Во-первых, необходимо установить и попытаться
ликвидировать этиологический фактор, явившийся непосредственной
причиной развития анемии. Если проблема выходит за рамки компетенции
терапевта, то пациенты могут потребовать внимания других специалистов
(гастроэнтерорлога, гинеколога\уролога, хирурга\проктолога и др.). Во-
вторых, терапевтическая тактика должна быть направлена не только на
нормальзацию уровня эритроцитов и гемоглобина, но и на восполнение
уровня запасов железа в депо. Для этого пациентам рекомендуют
придерживаться диеты с повышенным содержанием продуктов, богатых
железом (красное мясо, сушеные грибы, морская капуста, печень, сердце,
гречневая крупа, какао, зелень петрушки). Однако купировать
железодефицитную анемию только диетой невозможно, поэтому в
17

обязательном порядке назначаются железосодержащие лекарственные средства. Выбор конкретного препарата является одним из главных этапов успешного лечения пациентов с железодефицитной анемией.
Как известно, препараты железа выпускаются в 2 формах – для приема per os и для парентерального введения. Препараты для приема внутрь содержат железо в виде двух- и трехосновной модификации этого элемента.
Метаболизм двухвалентного железа, попавшего в организм, сводится к последовательной конвертации его из двухвалентного в трехвалентное, а
затем – снова в двухвалентное, используемое непосредственно в процессе эритропоэза. Таким образом, при поступлении в организм трехвалентного железо, количество необходимых метаболических реакций уменьшается,
конвертация происходит однократно до двухвалентного железа, что может рассматриваться как одно из преимуществ препаратов трехвалентного железа.
На сегодняшний день различий по скорости насыщения железом организма препаратами двух- и трехвалентного железа не отмечается.
Однако, следует помнить, что пероральный прием препаратов двухвалентного железа может сопровождаться запором, окрашивать стул в черный цвет, вызывать потемнение зубов, поэтому принимать их следует не разжевывая. Препараты трехвалентного железа лишены этих побочных эффектов, ввиду более высокого сродства этой формы к ферритину, где железо содержится именно в трехвалентной модификации.
Дозировка элементарного железа для взрослых в среднем составляет 100200 мг в сутки. Длительность назначения препаратов железа измеряется несколькими месяцами и имеет своей целью не только восстановление уровня гемоглобина и эритроцитов до нормальных значений, но и восполнение запасов железа в депо. Поэтому, стандартной схемой лечения является длительное (как правило, в течение нескольких месяцев) назначение препаратов железа в среднетерапевтических дозах ежедневно, вплоть до восстановления всех необходимых показателей, нарушенных при
18

железодефицитной анемии – уровень гемоглобина, эритроцитов, ОЖСС,
ферритина, трнасферрина. Показатель сывороточного железа при этом не имеет диагностического значения, поскольку на фоне приема препаратов он всегда остается в пределах нормы, либо повышенным. В течение первых двух недель после начала курса терапии препаратами железа в гемограмме регистрируется ретикулоцитоз – явление повышенного содержания ретикулоцитов в периферической крови. Данный факт, как правило, отражает верное направление в лечении пациента с анемией.
В основном, при выборе железосодержащего препарата предпочтение отдают пероральным формам. В случае нарушения процессов всасывания в ЖКТ (синдром мальабсорбции, резекция тонкого кишечника, энтериты,
обострения язвенных заболеваний ЖКТ), при непереносимости препаратов железа для приема внутрь целесообразно применение парентеральных форм железосодержащих лекарственных средств. Следует отметить, что скорость
купирования анемического и сидеропенического синдромов не зависит
от формы введения железосодержащего препарата.
Для применения парентеральных препаратов железа разработано ряд формул, позволяющих вычислить необходимое количество элементарного железа (т.е. конкретного препарата) для купирования состояния анемии. При этом учитывается исходный уровень гемоглобина у больного, его масса тела.
Однако ориентация на расчетные данные необходимого количества железа целесообразна лишь в том случае, когда врач уверен в отсутствии продолжающихся кровопотерь у пациента. В противном случае рассчитанная доза не сможет покрыть потребности железа в организме.
Терапевтическая цель парентеральных препаратов железа аналогична таковой при назначении пероральных форм, поэтому в ходе лечения необходимо следить не только за параметрами уровня гемоглобина и количества эритроцитов, но также и за показателями трансферрина,
ферритина и общей железосвязывающей способности сыворотки, которые
19